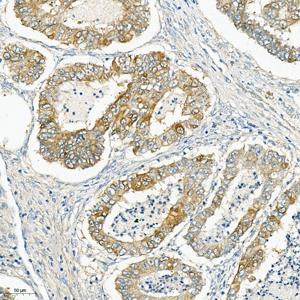
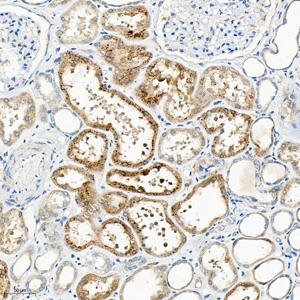
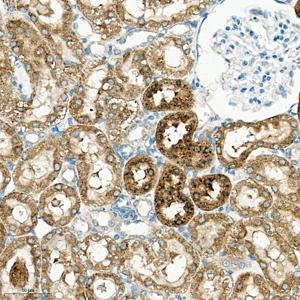

Anti-Cathepsin L/MEP Rabbit pAb
- 100 μL
产品信息
蛋白质全称 | 组织蛋白酶原L |
别名 | Cathepsin L, cathepsin L1, CATL, CTSL, CTSL1, FLJ31037, Major excreted protein, MEP |
免疫原 | KLH偶联的小鼠CathepsinL合成肽 |
Uniprot ID | P06797 |
抗体亚型 | IgG |
纯化方式 | 亲和纯化 |
亚细胞定位 | 溶酶体, 顶端细胞膜, 胞质囊泡, 分泌型, 细胞核 |
应用
| 应用 | 物种 | 稀释 | 阳性样品 |
| IHC/IF 免疫组织化学/免疫荧光 | 人, 小鼠, 大鼠 | 1: 50-1: 150 | 肝, 肾, 心 |
背景
Thiol protease important for the overall degradation of proteins in lysosomes. Involved in the solubilization of cross-linked TG/thyroglobulin and in the subsequent release of thyroid hormone thyroxine by limited proteolysis of TG/thyroglobulin in the thyroid follicle lumen. In neuroendocrine chromaffin cells secretory vesicles, catalyzes the prohormone proenkephalin processing to the active enkephalin peptide neurotransmitter. In thymus, regulates CD4 T cell positive selection by generating the major histocompatibility complex class II bound peptide ligands presented by cortical thymic epithelial cells. Also mediates invariant chain processing in cortical thymic epithelial cells.
图像
| IHC检测Cathepsin L/MEP蛋白(货号 GB115577). 样品: 人子宫内膜癌, 4%多聚甲醛 (货号G1101) 固定12-24小时. 抗原修复: Tris-EDTA抗原修复液(pH 9.0) (G1203), 98℃, 20分钟. —抗: 1: 150稀释, 4℃ 孵育过夜. 二抗: HRP标记山羊抗兔IgG (H+L) (货号GB23303), 1: 200稀释, 室温孵育1小时. |
| IHC检测Cathepsin L/MEP蛋白(货号 GB115577). 样品: 人肾, 4%多聚甲醛 (货号G1101) 固定12-24小时. 抗原修复: Tris-EDTA抗原修复液(pH 9.0) (G1203), 98℃, 20分钟. —抗: 1: 150稀释, 4℃ 孵育过夜. 二抗: HRP标记山羊抗兔IgG (H+L) (货号GB23303), 1: 200稀释, 室温孵育1小时. |
| IHC检测Cathepsin L/MEP蛋白(货号 GB115577). 样品: 人肝, 4%多聚甲醛 (货号G1101) 固定12-24小时. 抗原修复: Tris-EDTA抗原修复液(pH 9.0) (G1203), 98℃, 20分钟. —抗: 1: 150稀释, 4℃ 孵育过夜. 二抗: HRP标记山羊抗兔IgG (H+L) (货号GB23303), 1: 200稀释, 室温孵育1小时. |
| IHC检测Cathepsin L/MEP蛋白(货号 GB115577). 样品: 小鼠肾, 4%多聚甲醛 (货号G1101) 固定12-24小时. 抗原修复: Tris-EDTA抗原修复液(pH 9.0) (G1203), 98℃, 20分钟. —抗: 1: 150稀释, 4℃ 孵育过夜. 二抗: HRP标记山羊抗兔IgG (H+L) (货号GB23303), 1: 200稀释, 室温孵育1小时. |
| IHC检测Cathepsin L/MEP蛋白(货号 GB115577). 样品: 小鼠骨骼肌, 4%多聚甲醛 (货号G1101) 固定12-24小时. 抗原修复: Tris-EDTA抗原修复液(pH 9.0) (G1203), 98℃, 20分钟. —抗: 1: 150稀释, 4℃ 孵育过夜. 二抗: HRP标记山羊抗兔IgG (H+L) (货号GB23303), 1: 200稀释, 室温孵育1小时. |
| IHC检测Cathepsin L/MEP蛋白(货号 GB115577). 样品: 大鼠心, 4%多聚甲醛 (货号G1101) 固定12-24小时. 抗原修复: Tris-EDTA抗原修复液(pH 9.0) (G1203), 98℃, 20分钟. —抗: 1: 150稀释, 4℃ 孵育过夜. 二抗: HRP标记山羊抗兔IgG (H+L) (货号GB23303), 1: 200稀释, 室温孵育1小时. |
| IHC检测Cathepsin L/MEP蛋白(货号 GB115577). 样品: 大鼠肾, 4%多聚甲醛 (货号G1101) 固定12-24小时. 抗原修复: Tris-EDTA抗原修复液(pH 9.0) (G1203), 98℃, 20分钟. —抗: 1: 150稀释, 4℃ 孵育过夜. 二抗: HRP标记山羊抗兔IgG (H+L) (货号GB23303), 1: 200稀释, 室温孵育1小时. |
| IHC检测Cathepsin L/MEP蛋白(货号 GB115577). 样品: 大鼠骨骼肌, 4%多聚甲醛 (货号G1101) 固定12-24小时. 抗原修复: Tris-EDTA抗原修复液(pH 9.0) (G1203), 98℃, 20分钟. —抗: 1: 150稀释, 4℃ 孵育过夜. 二抗: HRP标记山羊抗兔IgG (H+L) (货号GB23303), 1: 200稀释, 室温孵育1小时. |
储存
| 储存条件 | 在-20℃下储存一年, 避免反复冻融. |
| 储存缓冲液 | 含0.15% ProClin300防腐剂, 100 μg/mL牛血清白蛋白和50%甘油的磷酸盐缓冲液. |
注意:
1.本产品仅供研究使用.
2.建议用一抗稀释液(G2025)稀释本产品.
| 货号 | 名称 | 规格 | 价格 | 操作 |
|---|
| 货号 | 名称 | 规格 | 价格 | 操作 |
|---|